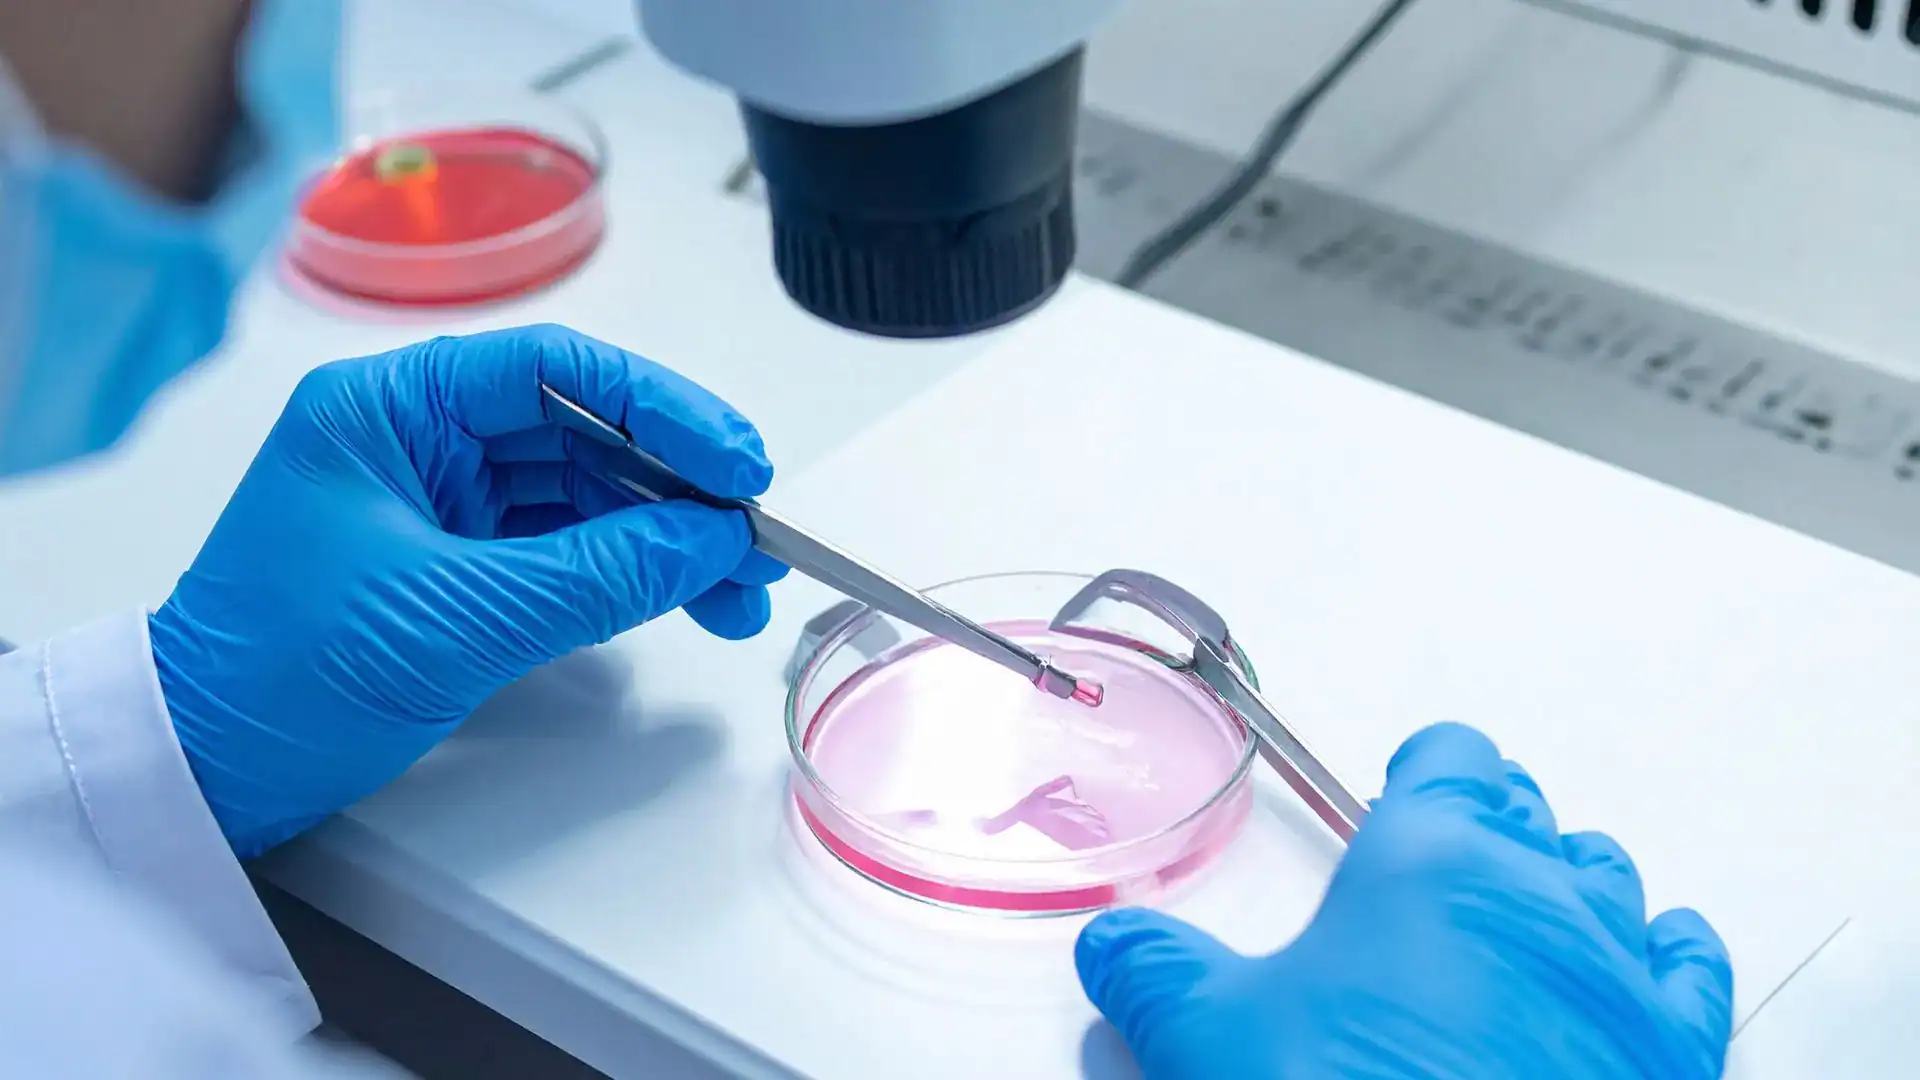
Egg freezing Brisbane

Egg freezing Brisbane: Your guide to preserving fertility at Eve Health
Exploring egg freezing in Brisbane? Eve Health provides supportive, expert-led fertility care, helping you understand your options with clarity, compassion, and medical precision.
Preserving your fertility, on your terms
Deciding to search for egg freezing often follows a period of reflection. Maybe you are not ready for a family right now, but want to keep your options open for the future. Perhaps you have health concerns, a family history of early menopause, or are preparing for medical treatment that could affect your fertility.
The decision to freeze your eggs is deeply personal, and it’s about giving yourself more choices, no matter what life brings.
Fertility preservation is about your story, not just science
Our team of registered fertility and women’s health practitioners provides evidence-based care that is tailored to your individual circumstances. Whether you’re exploring your options or ready to begin, we meet you where you are, with no assumptions and no pressure.
Our fertility specialists support women in planning for their future through evidence-based fertility preservation options. Your treatment is informed by clinical assessment and personal goals discussed during consultation.
There are usually several ways to move forward. IVF Brisbane might be one option, but not always the first or only one. We talk through all the fertility treatments that might suit your situation, using plain language, and give you time to ask anything. You will never be pressured or rushed to make a decision on the spot.
Egg freezing process
What to expect if you are considering egg freezing
At Eve Health, we support people from all backgrounds, identities, and walks of life.
First conversations
Everyone’s story is different. When you come to us, we begin with a conversation. What brings you here? What are you hoping for? What concerns or questions do you have? You’ll have space to talk and time to think. Nothing rushed. Nothing overlooked.
Looking at your health
Egg freezing isn’t one-size-fits-all. We’ll take a full look at your health, arrange some simple blood tests and a pelvic ultrasound, and help you understand your ovarian reserve (how many eggs you have and their likely quality). We’ll also talk through any medical factors that could affect the process or your chances.
Our role is to provide clear, evidence-based information to help you understand your fertility preservation options.
Your options
Egg freezing is just one type of fertility preservation. There are other paths, including embryo freezing and ovarian tissue preservation, which might suit certain situations. We will discuss all the available options with you, using plain English, so you can make an informed choice. We support informed decision-making at your own pace, with respect for your autonomy and individual circumstances.
Fertility treatment Brisbane
Egg freezing Brisbane: what is involved
If egg freezing is the right choice for you, here is what the process usually looks like. Everyone’s experience is a bit different, but these are the main steps:
Hormone stimulation
For around 10 to 14 days, you will take daily hormone injections that help your ovaries produce more eggs than usual. We use blood tests and gentle ultrasound scans to monitor how your eggs are developing.
This part can feel intense, some days are fine, others less so. That’s why we recommend CHARLI, a secure app created by our team. CHARLI is designed to help you manage your fertility treatment schedule and plan. It does not replace medical advice.
Egg collection
When your eggs are ready, we schedule a short procedure under light anaesthetic at a nearby hospital. Using ultrasound guidance, your fertility specialist gently collects the eggs with a fine needle. Most people return home the same day. You may feel tired or sore, your specialist will discuss what to expect and monitor your recovery.
Freezing and storage
Once your eggs are collected, our laboratory team checks each one and prepares them for freezing using a rapid process called vitrification. This technology helps protect the eggs from damage and keeps them safely stored for future use. Your eggs are kept in a secure storage facility at our partner IVF clinic, with strict protocols for safety and identification.
What happens next?
Your frozen eggs can be stored for many years. When you are ready to use them, the process involves thawing the eggs, fertilising them with sperm (usually via IVF), and transferring any resulting embryos into your uterus. The timing, options, and likelihood of success are all things we will talk through with you, based on the latest evidence and your personal circumstances.
Fertility treatment Brisbane
Why consider egg freezing?
Egg freezing may offer an option for some women who wish to preserve fertility and explore family planning at a later stage. There are many reasons people consider this path:
- Focusing on study, career, or other personal goals
- Not yet having found the right partner
- Family history of early menopause
- Preparing for cancer treatment or other medical procedures that may affect fertility
- Wanting to reduce age-related fertility decline
Whatever your reasons, you deserve support and clear, honest information. Eve Health’s registered fertility practitioners include those involved in clinical research and medical education.
For more information about egg freezing and fertility preservation, you can also visit the Fertility Society of Australia, which provides a range of resources for patients.
How much does egg freezing cost in Brisbane?
The total cost of egg freezing includes:
- Initial consultations and fertility tests
- Medication for ovarian stimulation
- Monitoring (blood tests and ultrasounds)
- Day surgery for egg collection
- Anaesthetist and specialist fees
- Laboratory and storage costs
At Eve Health, we will provide you with a clear breakdown of all costs at the start, so you can plan ahead. Medicare rebates may be available in some situations, especially if you are undergoing medical treatment that threatens your fertility. If you have private health insurance, some hospital costs may be covered. Our team can talk you through the details based on your circumstances.
For a detailed guide on fertility costs, you can read our costs and fees page or ask us at your first appointment.
Our team and care approach
Eve Health’s team of fertility specialists, nurses, GPs, and allied health professionals work together to provide a seamless experience. Many of our team have trained internationally and are active in research, teaching, and clinical trials. Our Spring Hill clinic offers women’s health services in a private setting with access to a multidisciplinary team.
When you come to Eve Health for egg freezing, you have access to:
- Advanced ultrasound and laboratory technology
- Onsite counselling and mental health support
- Education sessions on fertility, wellness, and planning
Care is provided by registered medical practitioners with CREI accreditation, recognising formal advanced training in reproductive endocrinology and infertility.
We work closely with Monash IVF. Our specialists are also accredited at major hospitals including the Mater and Mater Mothers. This means your care is coordinated, and you don’t need to travel far for different parts of your treatment.
Egg freezing Brisbane: frequently asked questions
1. How long can eggs be frozen for?
2. What is the best age to freeze eggs?
3. Are there risks or side effects?
4. How many eggs should I freeze?
5. Can I use my eggs if I move or change clinics?
IVF clinic Brisbane
Finding support with egg freezing
Thinking about egg freezing is a big step, and it’s normal to feel a mix of hope, anxiety, or even relief just from making a plan. It can help to keep track of your cycles, symptoms, and thoughts as you go. Tools like CHARLI are designed to support you, especially if you want to share these patterns with your care team or bring them to your appointment.
You can also connect with support groups and counsellors if you want more emotional support. Your Eve Health team can suggest resources or just offer a listening ear.
Egg freezing Brisbane: ready when you are
If you’re considering fertility preservation, our team can provide information to support your decision-making process. You might find it helpful to:
- Use a tool like CHARLI to track your cycles and symptoms
- Write down questions, worries, or topics to discuss
- Bring a partner, friend, or support person to your consultation
You are welcome to contact Eve Health for an appointment when you are ready. Whether you want to start egg freezing, discuss your options, or simply have an open conversation, our team is here to listen and support you. We cannot guarantee outcomes, but we do promise clear answers, kindness, and care for your whole story, now and in the future.
Comments are closed.

